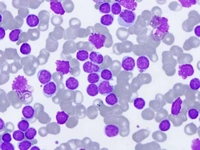
Lökosit Sayısı Kaçtır?

Bebeklerde Lökosit Düşüklüğü Belirtileri ve Tedavisi
Bebeklerde lökosit düşüklüğü, bağışıklık sisteminin zayıflamasına yol açabilir ve çeşitli sağlık sorunlarına neden olabilir. Bu makalede, bu durumun belirtileri, olası nedenleri ve tedavi yöntemleri hakkında bilgi verilmektedir. Erken tanı ve tedavi, bebek sağlığı için son derece önemlidir.
Bebeklerde lökosit düşüklüğü, immün sistemin bir göstergesi olan beyaz kan hücrelerinin (lökositlerin) sayısının normalin altına düşmesi durumudur. Bu durum, bebeklerin enfeksiyonlara karşı direncini azaltabilir ve çeşitli sağlık sorunlarına yol açabilir. Bu makalede, bebeklerde lökosit düşüklüğünün belirtileri, olası nedenleri ve tedavi yöntemleri üzerinde durulacaktır. 1. Lökosit Düşüklüğünün BelirtileriBebeklerde lökosit düşüklüğünün belirtileri, genellikle enfeksiyonların varlığı ile ilişkilidir. Bu belirtiler şunlardır:
Bu belirtiler bebeklerde acil tıbbi müdahale gerektirebilir. Eğer bir bebeğin lökosit sayısında bir düşüklük tespit edilirse, ebeveynlerin dikkatli olması ve belirtileri izlemeleri önemlidir. 2. Lökosit Düşüklüğünün Olası NedenleriBebeklerde lökosit düşüklüğünün çeşitli nedenleri olabilir. Bu nedenler arasında şunlar yer alır:
Bu nedenlerin tespiti için detaylı bir tıbbi değerlendirme ve laboratuvar testleri gereklidir. 3. Lökosit Düşüklüğünün TedavisiBebeklerde lökosit düşüklüğünün tedavisi, altta yatan nedene bağlı olarak değişkenlik gösterir. Genel tedavi yöntemleri arasında şunlar bulunur:
Tedavi süreci, bebeklerin genel sağlık durumuna ve lökosit düşüklüğünün nedenine bağlı olarak uzman hekim tarafından belirlenmelidir. 4. Önleyici TedbirlerBebeklerde lökosit düşüklüğünü önlemek için bazı tedbirler alınabilir:
Bu önlemler, bebeklerin genel sağlığını destekleyerek lökosit düşüklüğü riskini azaltabilir. Bebeklerde lökosit düşüklüğü, ciddi sağlık sorunlarına yol açabileceğinden, belirtiler izlendiğinde ve herhangi bir endişe durumunda mutlaka bir sağlık uzmanına başvurulmalıdır. Erken teşhis ve uygun tedavi yöntemleri, bebeklerin sağlığını korumada kritik bir rol oynamaktadır. |

Bebeğimde sürekli ağlama ve uyku problemleri yaşadığımda, bunun lökosit düşüklüğü ile ilgili olabileceğini düşünüyorum. Çünkü bebeklerin bağışıklık sistemi, lökosit seviyeleriyle doğrudan bağlantılı. Lökositler, enfeksiyonlara karşı koruma sağladığı için eğer sayıları düşükse, bebeğim daha huzursuz olabilir. Bu durum, onun bağışıklık sisteminin zayıf olması nedeniyle sık hastalanmasına ve dolayısıyla da sürekli ağlamasına sebep olabilir. Acaba bu konuda bir doktora başvurmalı mıyım? Lökosit seviyelerinin kontrol edilmesi ve gerekli tedavi yöntemlerinin uygulanması, bebeğimin sağlığı için önemli olabilir. Ayrıca, beslenme ve hijyen konularına da dikkat etmemiz gerektiğini düşünüyorum. Beslenme alışkanlıkları, bağışıklık sistemini güçlendirmek için kritik bir rol oynuyor.
Sayın Hüseyin Gazi,
Bebeğinizin yaşadığı ağlama ve uyku problemleri gerçekten endişe verici olabilir. Bahsettiğiniz lökosit düşüklüğü, bağışıklık sistemi ile doğrudan bağlantılı olduğu için önemli bir konu. Lökositler, enfeksiyonlarla mücadelede kritik bir rol oynar ve seviyelerinin düşük olması, bebeğinizin daha fazla hastalanmasına yol açabilir.
Evet, bir doktora başvurmanız kesinlikle önerilir. Doktor, lökosit seviyelerini kontrol edebilir ve gerekirse tedavi yöntemlerini belirleyebilir. Ayrıca, bebeğinizin sağlık durumu ile ilgili daha detaylı bilgi almanızı sağlar.
Beslenme ve hijyen konularına dikkat etmeniz de son derece önemli. Sağlıklı beslenme, bağışıklık sistemini güçlendirmek için kritik bir unsurdur. Bebeğinizin beslenme alışkanlıklarını gözden geçirmek ve hijyen kurallarına uymak, onun sağlığını olumlu yönde etkileyebilir.
Umarım bebeğiniz en kısa zamanda sağlığına kavuşur.
Bebeğimde sürekli ağlama ve uyku problemleri var, acaba lökosit düşüklüğü olabilir mi?
Merhaba İkbâl, bebeklerde sürekli ağlama ve uyku problemleri çeşitli nedenlerden kaynaklanabilir. Löksit düşüklüğü de bu nedenlerden biri olabilir, ancak kesin tanı için bir doktora başvurmanız çok önemli. Doktorunuz gerekli testleri yaparak durumu değerlendirecektir. Ayrıca, bebeklerin sıkça yaşadığı kolik, gaz sancısı gibi sorunlar da bu tür belirtilere yol açabilir. En doğru teşhis ve tedavi için uzman bir sağlık profesyoneline danışmanızı tavsiye ederim. Sağlıklı günler dilerim.